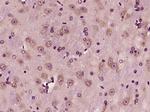
DGKB Antibody in Immunohistochemistry (Paraffin) (IHC (P))
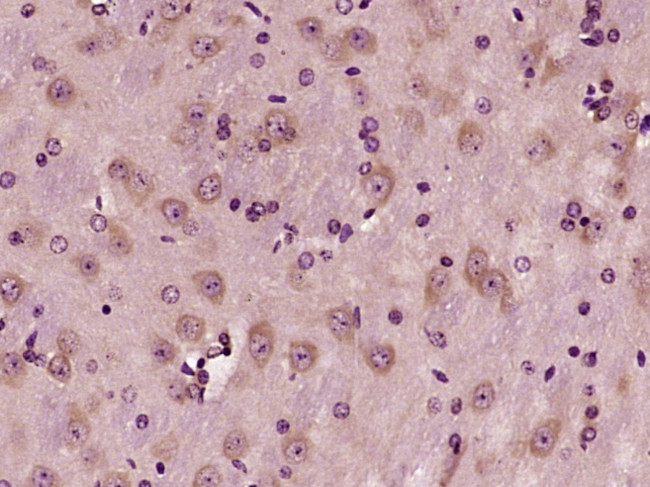
DGKB Antibody in Immunohistochemistry (Paraffin) (IHC (P))

Search
Bioss
DGKB Polyclonal Antibody
{{$productOrderCtrl.translations['antibody.pdp.commerceCard.promotion.promotions']}}
{{$productOrderCtrl.translations['antibody.pdp.commerceCard.promotion.viewpromo']}}
{{$productOrderCtrl.translations['antibody.pdp.commerceCard.promotion.promocode']}}: {{promo.promoCode}} {{promo.promoTitle}} {{promo.promoDescription}}. {{$productOrderCtrl.translations['antibody.pdp.commerceCard.promotion.learnmore']}}
图: 1 / 1
DGKB Antibody (BS-14295R) in IHC (P)
产品信息
BS-14295R
种属反应
宿主/亚型
分类
类型
抗原
偶联物
形式
浓度
规格
纯化类型
保存液
内含物
保存条件
运输条件
靶标信息
Diacylglycerol (DAG) is an allosteric activator of protein kinase C. DAG also participates in regulating RAS and RHO family proteins by activating the guanine nucleotide exchange factors VAV and RASGRP1. DAG is also involved in the synthesis of phospholipids and triacylglycerols. Tight regulation of DAG levels is achieved via DAG kinases (DGKs), which remove DAG by phosphorylate it to phosphatidic acid. Several mammalian isozymes of DAGK have been identified.
仅用于科研。不用于诊断过程。未经明确授权不得转售。
篇参考文献 (0)
生物信息学
蛋白别名: 90 kDa diacylglycerol kinase; DAG kinase beta; DGK-beta; Diacylglycerol kinase 90kDa; Diacylglycerol kinase beta; diacylglycerol kinase beta, 90kDa; diacylglycerol kinase, beta 90kDa; Diglyceride kinase beta; unnamed protein product
基因别名: 6430574F24; 90kda; C630029D13Rik; Dagk; DAGK2; DGK; DGK-BETA; DGKB; KIAA0718; mKIAA0718
UniProt ID: (Human) Q9Y6T7, (Rat) P49621, (Mouse) Q6NS52
Entrez Gene ID: (Human) 1607, (Rat) 54248, (Mouse) 217480